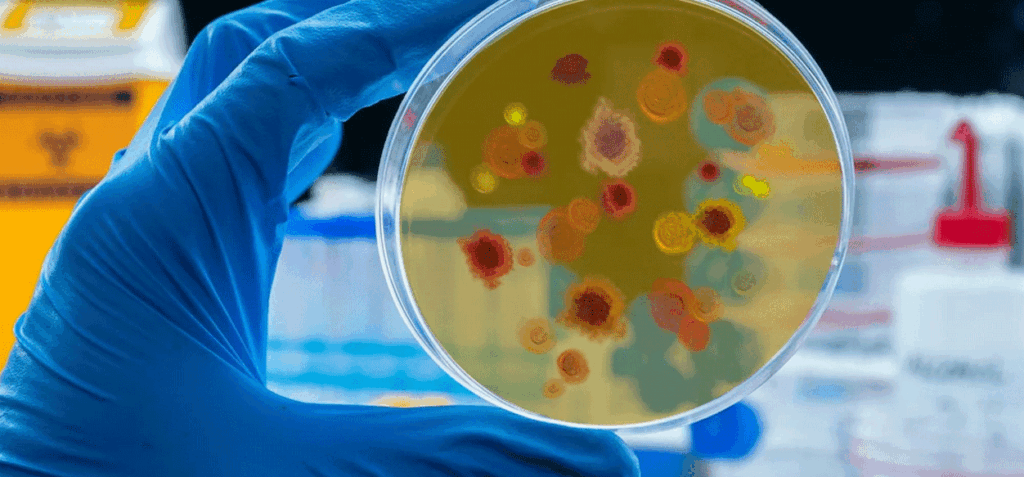

Las pruebas iniciales mostraron que esta molécula no solo redujo marcadores de inflamación celular, sino que también bloqueó y eliminó células de cáncer de pulmón en experimentos de laboratorio
Científicos hallan en un hongo una molécula con potencial contra el cáncer – Un equipo de científicos de la Universidad Nacional de Taiwán y de la Universidad Nacional Yang Ming Chiao Tung reportó el descubrimiento de un hongo poco común con propiedades que podrían abrir nuevas vías en la lucha contra el cáncer.
El hallazgo fue difundido en portales científicos como Science Alert y se centra en el Antrodia cinnamomea, también conocido como Taiwanofungus camphoratus, una especie originaria de los bosques de Taiwán.
Este hongo llamó la atención de los investigadores por su capacidad de producir un grupo de compuestos llamados polisacáridos sulfatados (SPS). Entre ellos destaca el galactoglucano sulfatado, una molécula que combina glucosa, galactosa y sulfato, y que, según estudios publicados en ScienceDirect, presenta propiedades antiinflamatorias y anticancerígenas.
Para profundizar en su potencial, los especialistas desarrollaron un método capaz de estimular al hongo y así incrementar la producción de SPS. De ese proceso surgió un compuesto identificado como N50 F2.
Leer también: Una nueva isla emerge en Alaska: el histórico hallazgo registrado por la NASA
La relevancia de este hallazgo radica en su mecanismo de acción. Tal como explicó la profesora Sherry Gao, experta en bioingeniería de la Universidad de Pensilvania, “las células cancerígenas se multiplican sin control gracias a los microtúbulos, estructuras esenciales para su división”.
Además, el compuesto obtenido del Antrodia cinnamomea interfiere precisamente en esa etapa, impidiendo que las células continúen reproduciéndose.
El farmacéutico Chia-Chuan Chang, de la Universidad Nacional de Taiwán, resaltó que la identificación de estas moléculas abre un escenario prometedor para la medicina moderna: “Con un proceso de producción controlado y escalable, vemos un futuro en el que estos compuestos puedan aplicarse tanto en suplementos de salud como en terapias clínicas contra el cáncer”, afirmó el investigador.
Finalmente, los resultados son preliminares y requieren más pruebas antes de convertirse en tratamientos oficiales.
EO// con información de: NTNT24
